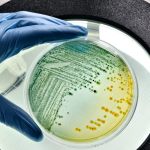

Cuando se habla de genética, es común que se sitúen en un nivel de equivalencia el genoma de un organismo y el código genético. Se asume que ambos términos son sinónimos, pero en realidad, son tan distintas entre sí como la historia que cuenta un libro y el idioma en el que está escrito.
El genoma es el conjunto de genes, las instrucciones que forman un ser vivo. Cada gen está formado por una serie de nucleótidos, las unidades básicas, como las letras que forman el mensaje, los eslabones en la cadena de ADN. El código genético es la forma en la que esos eslabones, convertidos en ARN mensajero, y distribuidos de tres en tres —se denominan codones—, tienen su equivalencia en un aminoácido que formará, durante la traducción, una proteína. En el símil con un libro, efectivamente, el genoma es el mensaje del libro, mientras que el código genético es el idioma, que es necesario conocerlo para comprender dicho mensaje.
Hasta ahora sabíamos que el genoma, ese mensaje de instrucciones, podía editarse con herramientas como CRISPR, descubierta por el español Francisco Martínez Mojica. Pero ¿qué hay del código genético? ¿Se puede alterar el idioma con el que se interpretan esas instrucciones?

Las propiedades del código genético
En general se afirma que el código genético tiene una serie de propiedades.
Por un lado, es un código degenerado. Hay un total de 64 codones posibles, hay 64 ‘palabras’ en el código genético, que son el resultado de todas las permutaciones posibles de las cuatro letras del código, A, C, U y G, distribuidas en grupos de tres en tres. Son muchos más que los 20 aminoácidos proteicos disponibles, por lo que varios codones son redundantes y codifican para un mismo aminoácido, por ejemplo, los codones AGU, AGC, UCU, UCC, UCA y UCG codifican, todos, para el aminoácido serina.
Además, es unívoco, es decir, que un codón siempre codifica para un mismo aminoácido; UCC codifica para serina, y solo para serina.
Otra propiedad es su continuidad; el mensaje no contiene espacios en blanco o pausas, a menos que se forme un codón específico para ello. Hay tres ‘palabras’ que indican el final de la lectura: UAA, UAG, UGA. Se denominan “codones STOP”.
La cuarta propiedad es que el código genético es universal, es decir, todos los seres vivos tienen el mismo código. O lo que es lo mismo, que UCC codifica para la serina en un elefante y también en una bacteria. Aunque esto no es del todo cierto.
Universal… pero no tanto
El código empleado por casi todas las formas de vida eucariotas es el mismo, denominado código estándar, pero existen variantes. Hay al menos 13 códigos distintos entre las mitocondrias de distintos grupos, además de los que se muestran en cloroplastos, bacterias, varios protistas y levaduras. Hasta donde sabemos, hay al menos 23 códigos genéticos distintos. Con este conocimiento en la mano, surgió una nueva curiosidad. ¿Podrían existir códigos genéticos artificiales?

En el año 2019, un grupo de investigadores liderados por Jason W. Chin, de la Universidad de Cambridge (Reino Unido) logró un avance muy peculiar. Desarrollaron una cepa de Escherichia coli con un genoma sintético de unos cuatro millones de pares de bases, en el que alteraron más de 18 000 posiciones del ADN original. El cambio consistió en eliminar algunos de los codones redundantes, como los que codifican para el aminoácido serina, y los sustituyeron por otros que mantuvieran el mismo significado. Redujeron las combinaciones de 64 codones posibles, a 61.
El resultado del cambio reduce la cantidad de recursos necesarios para la bacteria; para cada codón es necesario un fragmento de ARN de transferencia que porte un anticodón correspondiente. Pero esta nueva bacteria de genoma sintético no necesitaba 64 anticodones de ARNt, sino solo 61. Podían, por tanto, eliminar también los genes que codificaban la síntesis de esos fragmentos de ARN ahora innecesarios. Estas bacterias, cuya cepa recibe la denominación E. coli Syn61, hablan un dialecto al que le faltan tres ‘palabras’. Un código genético artificial e incompleto.
Este fenómeno resultó ser una ventaja a la hora de resistir el ataque de los virus. Cuando un virus infecta a una célula, inserta su material genético para hacer copias de sí mismo apoderándose de la maquinaria celular. Pero estas bacterias Syn61 ya no ‘hablan el mismo idioma’ que el virus. Al presentar el genoma del virus codones –‘palabras’– que no tienen significado en la bacteria, la misión del virus fracasa.

Inventando un nuevo idioma
El paso siguiente resulta lógico. Si hay tres codones que quedan libres, sin un aminoácido asignado: ¿podrían asignarse a ellos tres nuevos aminoácidos, distintos a los habituales?
Las proteínas de todos los seres vivos están formadas por 20 aminoácidos distintos, pero en la naturaleza existen muchos más, son los llamados aminoácidos no canónicos. Si encontrásemos los aminoácidos adecuados, e incorporamos estas instrucciones a un nuevo código genético– un idioma nuevo–, podríamos llegar a sintetizar proteínas que tengan aminoácidos no canónicos, extraños, que ninguna otra proteína tenga. Aminoácidos que puedan proporcionar propiedades nuevas a la proteína.
En 2021, el mismo grupo de investigación realizó una reasignación de codones para crear un idioma nuevo, sobre la bacteria Syn61. Tomaron esos tres codones vacíos y les dieron una nueva instrucción a cada uno. La bacteria resultante, que recibió el nombre de Syn61Δ3, fue capaz de sintetizar proteínas no canónicas.
Una preocupación existente era la posibilidad de que estos nuevos códigos genéticos pudieran ‘saltar’ a la naturaleza. Sin embargo, una investigación reciente ha mostrado que los propios códigos limitan la transferencia de información genética de los organismos sintéticos a los organismos naturales. Estos cortafuegos genéticos, como han sido denominados, aíslan los sistemas genéticos artificiales del entorno, y pueden ser de gran utilidad en el campo de la biocontención, por ejemplo, a la hora de aplicar estas funciones en condiciones fuera del laboratorio.
Estos descubrimientos abren nuevas puertas a la biotecnología. Ahora sabemos que no solo el genoma, el mensaje, puede editarse. También se puede editar el código genético, el idioma en el que se transcribe ese mensaje. Las potenciales aplicaciones de estos descubrimientos las conoceremos cuando el tiempo y la ciencia nos las muestren.
Referencias:
Fredens, J. et al. 2019. Total synthesis of Escherichia coli with a recoded genome. Nature, 569(7757), 514-518. DOI: 10.1038/s41586-019-1192-5
Robertson, W. E. et al. 2021. Sense codon reassignment enables viral resistance and encoded polymer synthesis. Science, 372(6546), 1057-1062. DOI: 10.1126/science.abg3029
Zürcher, J. F. et al. 2022. Refactored genetic codes enable bidirectional genetic isolation. Science, 378(6619), 516-523. DOI: 10.1126/science.add8943